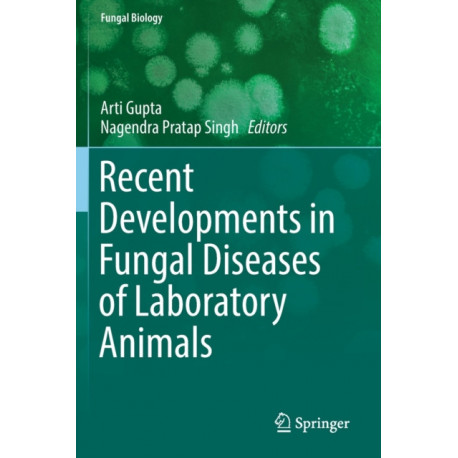

Kurv
Vare
varer
(tom)
Ingen varer
Fastlægges senere
Forsendelse
0,- kr
I alt
Recent Developments in Fungal Diseases of Laboratory Animals
(Bog, Paperback / softback, Engelsk)
Forlag:
Springer Nature Switzerland AG
- Type: Bog
- Format: Paperback / softback
-
Sprog:
Engelsk

- ISBN-13: 9783030185886
- Se flere detaljer ▼
Beskrivelse
Fungal growths affect both human and animal well-being. This book provides a valuable source of information to biologicaland biomedical scientists and to clinical and doctoral researchers working in the area of fungal infections and diseases of laboratory animal species.
Læsernes anmeldelser (0)
Alle detaljer
| Forlag | Springer Nature Switzerland AG |
| Type | Bog |
| Format | Paperback / softback |
| Sprog | Engelsk |
| Udgave | 2019 ed. |
| Udgivelsesdato | 14-08-2020 |
| Første udgivelsesår | 2020 |
| Serie | Fungal Biology |
| Illustrationer | 23 Illustrations, color; 3 Illustrations, black and white |
| Fagredaktør | Arti Gupta, Nagendra Pratap Singh |
| Originalsprog | Switzerland |
| Sideantal | 169 |
| Indbinding | Paperback / softback |
| Forlag | Springer Nature Switzerland AG |
| Sideoplysninger | 169 pages, 23 Illustrations, color; 3 Illustrations, black and white |
| Mål | 155 x 236 x 15 |
| ISBN-13 / EAN-13 | 9783030185886 |

